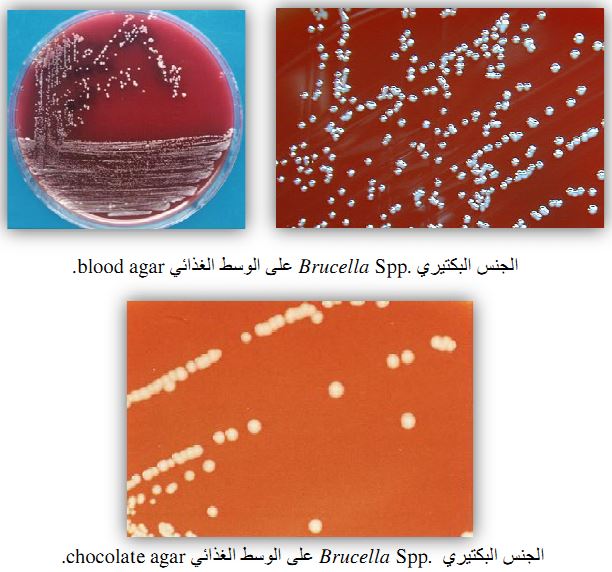

النبات

مواضيع عامة في علم النبات

الجذور - السيقان - الأوراق

النباتات الوعائية واللاوعائية

البذور (مغطاة البذور - عاريات البذور)

الطحالب

النباتات الطبية


الحيوان

مواضيع عامة في علم الحيوان

علم التشريح

التنوع الإحيائي

البايلوجيا الخلوية


الأحياء المجهرية

البكتيريا

الفطريات

الطفيليات

الفايروسات


علم الأمراض

الاورام

الامراض الوراثية

الامراض المناعية

الامراض المدارية

اضطرابات الدورة الدموية

مواضيع عامة في علم الامراض

الحشرات


التقانة الإحيائية

مواضيع عامة في التقانة الإحيائية


التقنية الحيوية المكروبية

التقنية الحيوية والميكروبات

الفعاليات الحيوية

وراثة الاحياء المجهرية

تصنيف الاحياء المجهرية

الاحياء المجهرية في الطبيعة

أيض الاجهاد

التقنية الحيوية والبيئة

التقنية الحيوية والطب

التقنية الحيوية والزراعة

التقنية الحيوية والصناعة

التقنية الحيوية والطاقة

البحار والطحالب الصغيرة

عزل البروتين

هندسة الجينات


التقنية الحياتية النانوية

مفاهيم التقنية الحيوية النانوية

التراكيب النانوية والمجاهر المستخدمة في رؤيتها

تصنيع وتخليق المواد النانوية

تطبيقات التقنية النانوية والحيوية النانوية

الرقائق والمتحسسات الحيوية

المصفوفات المجهرية وحاسوب الدنا

اللقاحات

البيئة والتلوث


علم الأجنة

اعضاء التكاثر وتشكل الاعراس

الاخصاب

التشطر

العصيبة وتشكل الجسيدات

تشكل اللواحق الجنينية

تكون المعيدة وظهور الطبقات الجنينية

مقدمة لعلم الاجنة


الأحياء الجزيئي

مواضيع عامة في الاحياء الجزيئي


علم وظائف الأعضاء


الغدد

مواضيع عامة في الغدد

الغدد الصم و هرموناتها

الجسم تحت السريري

الغدة النخامية

الغدة الكظرية

الغدة التناسلية

الغدة الدرقية والجار الدرقية

الغدة البنكرياسية

الغدة الصنوبرية

مواضيع عامة في علم وظائف الاعضاء

الخلية الحيوانية

الجهاز العصبي

أعضاء الحس

الجهاز العضلي

السوائل الجسمية

الجهاز الدوري والليمف

الجهاز التنفسي

الجهاز الهضمي

الجهاز البولي


المضادات الميكروبية

مواضيع عامة في المضادات الميكروبية

مضادات البكتيريا

مضادات الفطريات

مضادات الطفيليات

مضادات الفايروسات

علم الخلية

الوراثة

الأحياء العامة

المناعة

التحليلات المرضية

الكيمياء الحيوية

مواضيع متنوعة أخرى

الانزيمات
الجنس Brucella Spp
المؤلف:
عبد الرزاق سليمان التومي ، محمد محمد الامام ، عبد الباسط رمضان
المصدر:
اساسيات التشخيص البكتريولوجي المعملي والسريري
الجزء والصفحة:
14-7-2016
3470
Brucella Spp
هذا الجنس البكتيري عبارة عن خلايا صغيرة سالبة لصبغة جرام. غير مكونة للحافظة ، غير متحركة ، وتكون هذه الخلايا على هيئة عصيات كروية أو عصيات قصيرة، وهو هوائي التغذية (عدا النوع البكتيري B. abortus فهو يحتاج لجو مشبع بغاز ثاني أكسيد الكربون)، ويمكن أن ينمو في درجات حرارة 40-20 درجة مئوية وتعتبر درجة الحرارة 37 درجة مئوية هي درجة الحرارة المثلى. تترك المزرعة البكتيرية لأربع أسابيع مع إعادة زراعتها على وسط غذائي صلب فإن المستعمرات البكتيرية ستظهر خلال يومين أو ثلاثة أيام من التحضين.

خلايا الجنس البكتيري Braucella Spp. باستعمال صبغة جرام
وهناك ثلاث انواع رئيسية من هذا النوع البكتيري هي B. melitensis وهو يصيب الماعز والخراف في دول حوض البحر المتوسط، والنوع البكتيري الثاني B. abortus وهو يصيب الماشية في أغلب دول العالم والنوع البكتيري الثالث وهو b. suis والذي يصيب الخنازير في أمريكا والدنمارك ، وكل نوع منهم يتضمن عدة أنواع حيوية biotype
الامراضية :
يصيب هذا الجنس البكتيري بصورة خاصة حيوانات المزرعة domestic animals لتنتقل الإصابة بعد ذلك للإنسان من خلال تناول الحليب غير المبستر على سبيل المثال أو أي من مشتقاته . ويسبب هذا النوع البكتيري الإصابة طويلة الامد مع حمى (الحمى المتموجة undulant ferver ).
ويعتبر مرض الحمى المتموجة brucellosis الذي كان يعرف بمرض Bang's disease في تسعينات القرن الثامن عشر "كما سبق وأن اطلق عليه اسم Malta fever بعد تفشي جانحة وبانية بين الجنود في جزيرة مالطا في ثمانينات القرن الثامن عشر " وهو من الأمراض التي تنتقل من الحيوان إلى الإنسان zoonosis نتيجة الإصابة بــ :
- النوع البكتيري B. melitensis وهو أكثر انواع هذا الجنس البكتيري وشيوعاً وأشدهم خطراً، وهذا النوع يصيب الماعز والخراف على وجه الخصوص، كما يمكن أن يصيب الأبقار وتحديداً في مزارع تربية الأبقار.
- النوع البكتيري B. abortus وهذا النوع غالباً ما يصيب الماشية ومن الممكن انتقاله لبقية الحيوانات بما في ذلك الخراف والماعز والحمال والكلاب.
- النوع البكتيري B. suis وهذا النوع يصيب الخنازير فقط.
مع ملاحظة أنه من النادر الإصابة بمرض الحمى المتموجة نتيجة النوع البكتيري B. canis الذي يصيب الكلاب فقط.
طبيعة هذا الجنس البكتيري التواجد داخل الخلايا intracellular وهو يصيب الخلايا الشبكية المبطنة للطحال والكبد والكلى ونخاع العظم، ومن هذه المواضع تنتقل البكتريا إلى الدم، ويتصف هذا المرض بحمى اما متواصلة أو منقطعة او متموجة وغير محددة وأعراض الإصابة الحادة acute infection قد تشبه أعراض مرض الإنفلونزا الشديدة وذلك بظهور صداع في الرأس والتعرق الليلي والإعياء مع الشهور بالوهن وفي بعض الأشخاص قد تظهر أعراض لها علاقة بالجهاز البولي والتناسلي ومن النادر ظهور أعراض لها علاقة بالجهازالعصبي . في الغالب الشخص المصاب تظهر عليه أعراض فقر الدم anemic وكذلك عوز كرات الدم البيضاء leukopenic مع زيادة نسبية في الخلايا الليمفاوية lymphocytosis ، والحالات التي لم تعالج من الممكن أن تتحول إلى حالات مزمنة يصاحبها أعراض في الجهاز العضلي كآلام الظهر back pain وإلهاب المفاصل arthritis وآلام المفاصل arthralgia وقد تصل الإصابة إلى صمامات القلب ما ينتج عنها التهاب بطانة القلب endocarditis، ومن غير المستبعد حدوث بعض الامراض المناعية immune complex syndrome.

الحمى المتموجة undulant عند الإصابة بداء الحمى المتموجة.
تحدث الإصابة نتيجة تناول الحليب الخام أو الجبن أو أي من مشتقات الحليب الأخرى الملوثة بالجنس البكتيري . Brucella Spp حيث إن أعداد كبيرة من هذه البكتريا ممرضة تتواجد في حليب الحيوان المصاب ولها القدرة على إحداث الإصابة من خلال خدوش الجلد او العين أو حتى من خلال الاشتقاق ، وبالتالي فإن الاشخاص المتعاملين مع الحيوانات أكثر عرضة للإصابة بهذا المرض. يتوطن هذا المرض في المناطق التي لم يتم فيها القضاء على الحيوانات المصابة وتحديداً في دول حوض البحر المتوسط والشرق الأوسط وغرب آسيا وبعض مناطق أفريقيا وأمريكا اللاتينية .
يتأثر الجنس البكتيري Brucella Spp . بالعديد من المضادات الحيوية التي يمكن استعمالها لعلاج الإصابة بمرض الحمى المتموجة ، إلا أن تواجده داخل الخلايا intracellular يجعل من الصعب التخلص منه. كوسيلة للعلاج يمكن تناول المضاد الحيوي tetracycline مع المضاد الحيوي Streptomycin.
التشخيص المعملي :
كل نوع من الجنس البكتيري Braucella Spp ينقسم إلى عدة انواع حيوية biotypes ، ويتم التفريق بين الانواع من خلال الاختبارات الكيموحيوية أو من خلال حساسيته لصبغات معينة، كما يمكن التفريق بينهم من خلال ارتفاع معدل المضاد المصلي antisera لمستضد النوع البكتيري B. melitensis أو النوع البكتيري B. abortus.
يجب الأخذ في الاعتبار أن الجنس البكتيري Brucella Spp معدي جداً (hazard ris; group3) وبالتالي لابد من اتباع احتياطات الامان الحيوي اللازمة، حيث تم توثيق العديد من حالات الإصابة المعملية الناتجة من الوخز وبالتالي يجب التأكد على الحيطة عند سحب عينة الدم والتقليل من نشر رذاذ العينة باستخدام كابينة السلامة safety cabinet.
يمكن الاعتماد على عينة الدم أو عينة نخاع العظم bone marrow في الطور الحاد من المرض وذلك لإجراء المزرعة البكتيرية ، مع العلم بأن هذا الجنس البكتيري يتضاعف بسرعة في مزرعة عينة نخاع العظم كما يمكن أن تنمو المستعمرات البكتيرية في الحالات التي تناول فيها الشخص المصاب المضاد الحيوي قبل أخذ العينة وهو ما يميز هذه العينة على عينة الدم. بينما عينة الدم تعطي نتيجة موجبة أفضل في حالات الإصابة الناتجة من جراء النوع البكتيري B. melitensis والنوع البكتري B. suis .
من الصعب عزل الانواع المختلفة من هذا الجنس البكتيري وخاصة النوع البكتيري B. abortus ، حيث من الممكن عزله من عينة الدم خلال نوبات الحمى في حالات الإصابة الحادة ومن النادر ان يتم عزله في الإصابات المزمنة.
ــ الوسط الغذائي tryptone soya (tryptic soy) diphasic medium: يفضل استعمال هذا الوسط لعزل الأنواع المختلفة من الجنس البكتيري Brucella Spp.
ــ الوسط الغذائي blood agar والوسط الغذائي chocolate agar : بعد التحضين في بيئة تحتوي على 10-5 % من غاز ثاني أكسيد الكربون ولمدة تزيد على 48 ساعة وقد تصل لمدة اسبوع فإن المستعمرات البكتيرية النامية ستكون دقيقة Poinpoint ، مرتفعة ولونها أبيض يميل لأن يكون غير ناصع creamy ، متلألأة glistening ، وليس لها القدرة على إحلال كريات الدم الحمراء non haemolytic . المستعمرات البكتيرية حديثة النمو يميل لونها للأصفر، وقد تكون غامقة اللون ومع مرور الوقت يتول لونها إلى البني.
يتم إعادة زراعة المستعمرات البكتيرية النامية subculturing على الوسط الغذائي glucose typtone agar المائل مع شريط مشبع بمادة lead anetate متبث على عنق الانبوية ليساعد في الكشف على انتاج كبريتيد الهيدروجين H2S، حيث أن نتيجة النوع البكتيري B. melitensis ستكون سالبة، بينما أغلب سلالات النوع البكتيري B. abortus والنوع البكتيري B. suis ستكون نتيجتها موجبة. كما يمكن الاعتماد على مدى قدرة النوع البكتيري على النمو في الوسط الغذائي typtone soya agar الذي يحتوي على تركيزات مختلفة من الصبغات مثل صبغة basic fuchsin وصيغة thionine في التفريق بين الانواع المختلفة لهذا الجنس البكتيري.
الاختبارات المعملية :
ــ اختبار الكشف على إنزيم oxidase : موجب (بعض سلالات النوع البكتيري B. abortus سالب).
ــ اختبار الكشف على إنزيم catalase : موجب.
ــ اختبار الكشف على تكون indole : سالب.
ــ اختبار الكشف على إنزيم urease : موجب .
الاختبارات المصلية :
يتم استعمال الاختبارات المصلية بالاعتماد على اختبار
Ig M /1gG immunochromatographic assay كما يمكن الاستعانة بهذا الاختبار في مراقبة مدى الاستجابة للعلاج، ويعتمد هذا الاختبار على تحديد الاجسام المضادة IgM والأجسام المضادة IgM المتعلقة بالجنس البكتيري Brucella Spp وتبقى الأجسام المضادة IgM التي تتكون في بداية الإصابة لمدة طويلة قد تصل لشهور بعد شفاء المريض. بينما الأجسام المضادة IgG والتي تتكون في مرحلة متأخرة يمكن أن تبقى لفترة قد تصل لعدة سنوات بعد الشفاء، وسيقل معدل هذه الأجسام المضادة خلال فترة العلاج وما بعدها لتصل إلى مستويات منخفضة قد لا يمكن تحديد وجودها. وتزداد دقة النتائج المتحصل عليها (لتصل إلى 100-96%) إذا ماتم الاعتماد على تحديد وجود الاجسام المضادة IgM والأجسام المضادة IgM معاً. في حالات الإصابة الحادة عندما يكون الشخص مصاب منذ شهرين فقط فإن الأجسام المضادة IgM هي التي من الممكن تحديد وجودها، ومع تقدم الوقت واستمرار الإصابة فسيبدأ في حالات الإصابة المزمنة.
كما ان اختبار التلازن agglutination test من الإختبارات المصلية الأخرى التي يمكن الاعتماد عليها في تشخيص مرض الحمى المتموجة وهي:
ــ rapid slide screening agglutination test
ــ tupe or microplate agglutination test
ويفضل استعمال كواشف المستضد Ag reagents التي تم تجهيزها من سلالات الجنس البكتيري Bruvella Spp المحلية.
الاكثر قراءة في البكتيريا
اخر الاخبار
اخبار العتبة العباسية المقدسة
الآخبار الصحية

قسم الشؤون الفكرية يصدر كتاباً يوثق تاريخ السدانة في العتبة العباسية المقدسة
"المهمة".. إصدار قصصي يوثّق القصص الفائزة في مسابقة فتوى الدفاع المقدسة للقصة القصيرة
(نوافذ).. إصدار أدبي يوثق القصص الفائزة في مسابقة الإمام العسكري (عليه السلام)